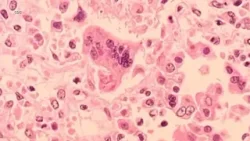
Highly-contagious measles case confirmed in one Bay Area county, health officials say

KGO-TV online - Tv na żywo

KGO-TV TV internetowa za darmo
Bądź na bieżąco z ABC7 News - KGO. Oglądaj transmisje na żywo i oglądaj telewizję online, aby otrzymywać najświeższe wiadomości, aktualizacje pogody i szczegółowe historie z obszaru Zatoki San Francisco. Dołącz do nas teraz, aby być na bieżąco z najnowszymi wydarzeniami w Twojej społeczności.
KGO-TV, znany jako ABC7 News, od wielu lat jest znanym i zaufanym kanałem telewizyjnym w rejonie Zatoki San Francisco. Jako wiodące źródło wiadomości i informacji, KGO-TV zapewnia transmisje na żywo i dostępność online, zapewniając, że widzowie są informowani i zaangażowani w najnowsze wydarzenia, najświeższe wiadomości, aktualizacje pogody i szczegółowe historie z ich społeczności i nie tylko.
U podstaw misji KGO-TV leży zaangażowanie w dostarczanie dokładnych i kompleksowych wiadomości. Zespół doświadczonych dziennikarzy i reporterów kanału pilnie pracuje nad dostarczaniem najnowszych wydarzeń i historii widzom w rejonie Zatoki San Francisco. Niezależnie od tego, czy chodzi o wiadomości lokalne, nagłówki krajowe czy sprawy międzynarodowe, KGO-TV zapewnia, że widzowie są dobrze poinformowani o wydarzeniach, które mają wpływ na ich życie i tętniącą życiem społeczność, którą nazywają domem.
Obszar Zatoki San Francisco jest znany z różnorodnych i ciągle zmieniających się wzorców pogodowych, a KGO-TV zdaje sobie sprawę, jak ważne są wiarygodne aktualizacje pogody. Meteorolodzy kanału zapewniają dokładne prognozy, śledzenie burz i porady dotyczące bezpieczeństwa związane z pogodą, pomagając widzom pozostać przygotowanym i bezpiecznym podczas trudnych warunków pogodowych. Koncentrując się na świadomości pogodowej, KGO-TV informuje społeczność i przygotowuje ją do radzenia sobie z różnymi wyzwaniami pogodowymi.
Poza wiadomościami i pogodą, KGO-TV stara się być gawędziarzem, który celebruje istotę San Francisco Bay Area. Poprzez angażujące historie o ludziach i segmenty fabularne, kanał oddaje wyjątkowego ducha, kulturę i różnorodność społeczności, którym służy. Od wyróżniania lokalnych bohaterów i inspirujących osób po prezentowanie wydarzeń kulturalnych i inicjatyw społecznych, KGO-TV przedstawia dynamiczny obraz życia w Bay Area.


